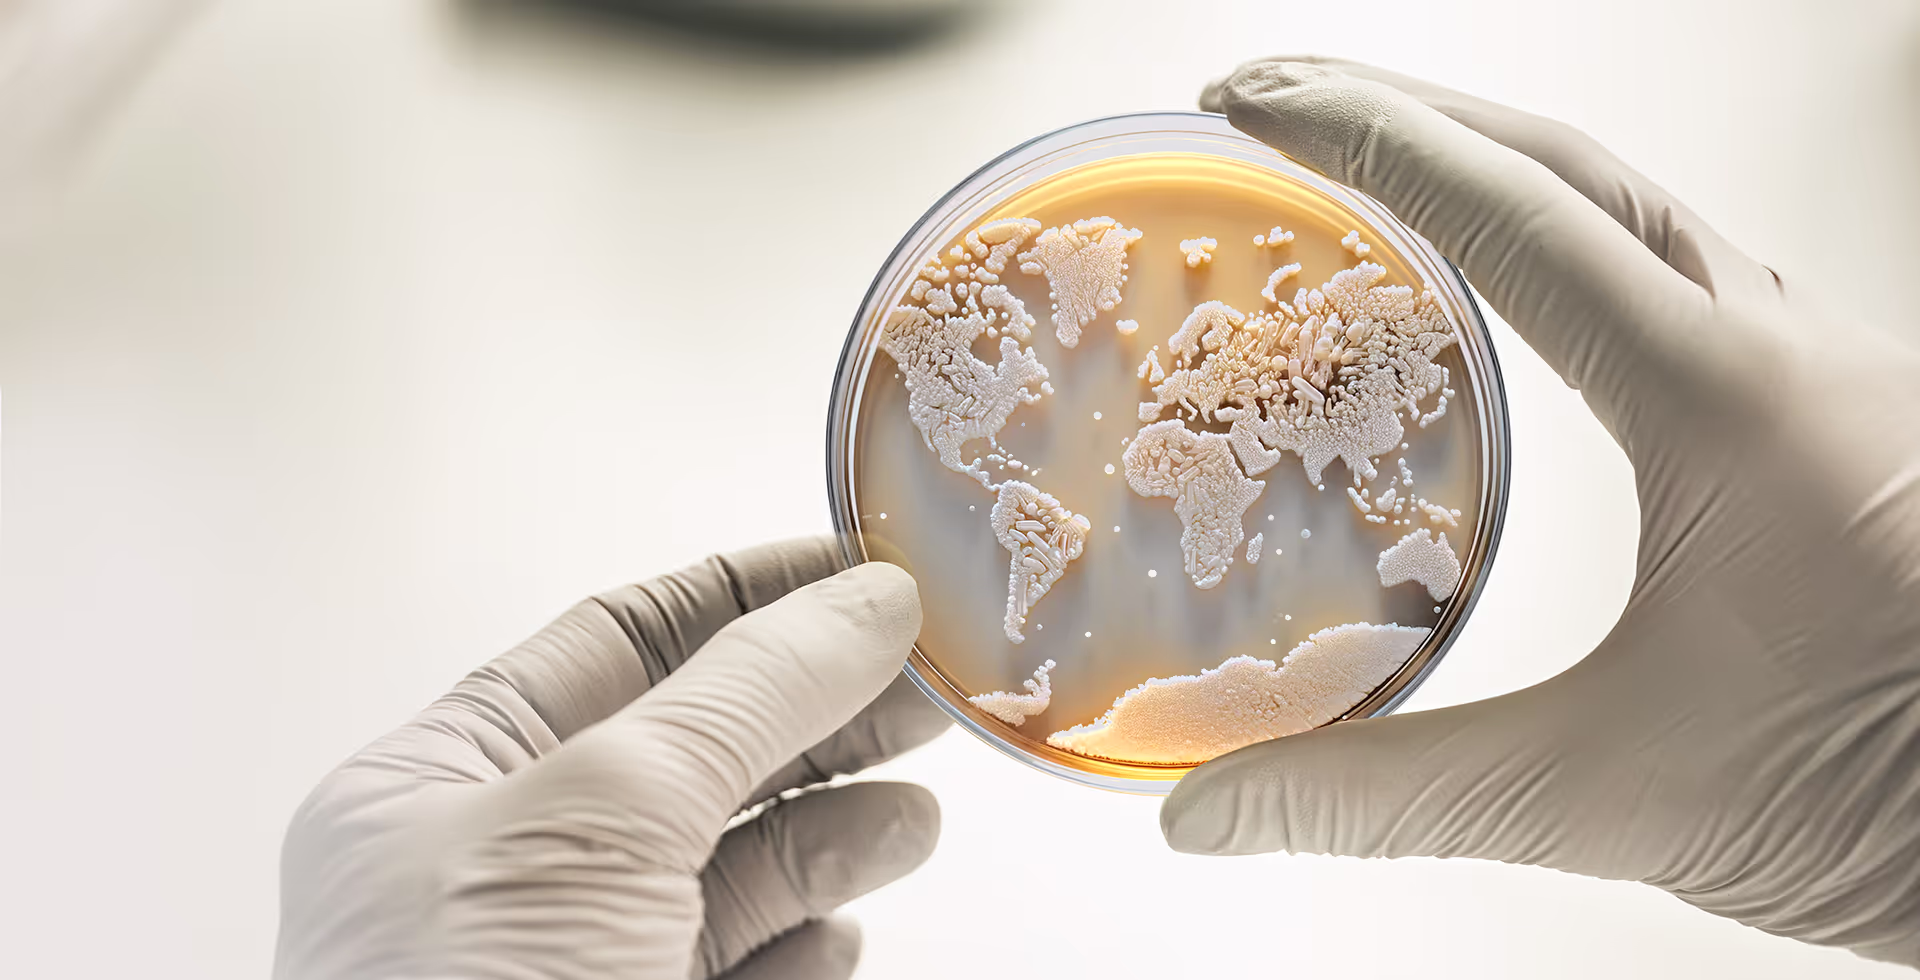
Petri dish with colonies in the shape of the world map

Our mission –
our vision
Founded in Bielefeld in 2000, PlasmidFactory GmbH is a leading contract development and manufacturing organization (CDMO) of plasmid and minicircle DNA, providing plasmids and related products to many major national and international customers working in the areas of gene and cell therapy, CAR-T cell development, and genetic vaccination.
Our modus operandi is to apply entrepreneurship to the service of science. We accept no compromises in either quality or competency, and our products and processes are continuously optimized and redeveloped as needed. Our ambition is to drive visionary research with new, compelling ideas and extraordinary techniques, and to foster progress in healthcare by providing customers with exceptionally pure plasmids and minicircle DNA with which to advance their clinical and research programs.
Our modus operandi is to apply entrepreneurship to the service of science.
PlasmidFactory partnered with ARCHIMED to accelerate the company’s expansion. With offices in Europe, North America and Asia, ARCHIMED is a leading global investment firm focusing exclusively on the healthcare industries.
We also co-operate with national and international partners.












In September 2022, PlasmidFactory partnered with ARCHIMED.
ARCHIMED is acting as a key catalyst for rapid and efficient capacity expansion, exemplified by helping the company move into GMP. Further, ARCHIMED continues PlasmidFactory’s decades of investment in the scientific development of plasmid DNA manufacturing and IP such as the minicircle, while scaling up the team for the next phase of growth.
With €7.5 billion assets under management across its various funds, ARCHIMED is a leading private equity firm dedicated to investing in the healthcare industries with prioritized areas of focus including Biopharma Products, Consumer Health, Healthcare IT, In Vitro Diagnostics, Life Science Tools & Biologic Services, MedTech, and Pharma Services.
ARCHIMED partners with growing companies in the European and North American mid-cap healthcare sectors, buying stakes in companies, in association with existing owners and managers. It brings decades of medical, scientific, operational, and financial experience, and has identified specific value creation levers to help accomplish its goals of accelerating the growth of its companies and ultimately improving patient outcomes.
It is precisely this diversity of expertise that allows us to tackle challenges from multiple angles.
Teamwork makes
the dream work
The PlasmidFactory team is made up of professionals from diverse scientific backgrounds, including biologists, biotechnologists, chemists, and engineers. It is precisely this diversity of expertise that allows us to tackle challenges from multiple angles using distinct approaches and developing innovative, tailored solutions to our customers‘ needs in collaboration with our own R&D department.
Our trademarks
PlasmidFactory holds worldwide trademark rights for the following technologies:
Our target: first-class end products of guaranteed quality, within a reasonable timeframe
Quality management

Our philosophy is to manufacture final products with defined quality features within a reasonable timeframe. Every production method is described in written instructions and all processes described in the QM manual are monitored and documented. Regulations in the form of binding SOPs are available for all quality-relevant activities and are continuously updated and expanded. Relevant regulations and statutory provisions are incorporated into our internal processes. All work is carried out by an appropriate number of trained and qualified employees, using suitable resources. This ensures the fulfillment of scientific tasks with the greatest possible expertise. Our organizational structure ensures the effective cooperation of all elements, ensuring optimal quality.
Get in touch!
Environment – social –
governance

At PlasmidFactory, we are committed to incorporating the key tenets of environmental and social governance into the services we provide, to ensure a better future for all. This includes reducing the impact of our operations to minimize negative environmental impacts and implementing sustainable, environmentally responsible practices; building a healthy organizational culture based on the integrity, accountability, and rigorous application of the highest ethical standards; and ensuring maximum transparency at all levels of corporate governance.
Ordering &
Shipping
PlasmidFactory has already produced more than 3,000 individual, distinct plasmids on customer request. We guarantee delivery of the quantity ordered.
Would you like to find out how you can benefit from PlasmidFactory’s service for the production of your individual plasmids and in-stock products? Take a look at our sample order process!

Shipment
| Zone | Destination | Price (€) |
|---|---|---|
Zone 1 | Destination Germany | Price (€) 100,00 |
Zone 2 | Destination Austria, Belgium, Czech Republic, Denmark, Estonia, Finland, France, Hungary, Ireland, Italy, Luxembourg, Poland, Portugal, Slovakia, Slovenia, Spain, Sweden, The Netherlands | Price (€) 275,00 |
Zone 3 | Destination Australia, Canada, China, Norway, Singapore, Switzerland, United Kingdom, USA | Price (€) 375,00 |
If your country or destination is not indicated above, please contact us.
Please note: for on-site collection of plasmids, a rate of $/€100 is applied.
Advance your application or research with plasmids designed and produced according to your needs.
We are aware of our responsibility towards our fellow human beings and the environment. We act in accordance with general ESG (Environmental Social Governance) criteria.